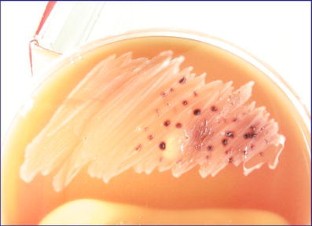

Abstract
A 6-year-old Holstein cow was referred for necropsy due to sudden death. The necropsy indicated hydroperitoneum, hydropericardium, and petechial hemorrhage on serosal surfaces associated with pulmonary edema and multiple abscesses in the liver. Histopathological examination revealed extensive hepatocellular necrosis with neutrophilic infiltrates and abscess formation. Cultures of the liver lesions and blood revealed a Gram-negative anaerobic bacteria confirmed as Bacteroides melaninogenicus.

References
Finegold SM (1977) Anaerobic bacteria in human disease. Academic Press, Inc., New York
Hagan WA, Bruner DW, Timoney JF (1988) Hagan and Bruner's microbiology and infectious diseases of domestic animals: with reference to etiology, epizootiology, pathogenesis, immunity, diagnosis and antimicrobial susceptibility., Cornell University Press
Hargis AN, Ginn PE (2007) The integument. In: McGavin MD, Zachary JF (eds) Pathologic basis of veterinary disease, 4th edn. Mosby, Inc., p. 1191
Hill GB, Osterhout S, Pratt PC (1974) Liver abscess production by non-spore-forming anaerobic bacteria in a mouse model. Infect Immun 9:599–603
McCallum RE, Roher MD, Urbaschek R, Urbaschek B (1982) Histopathology of mixed anaerobic intraabdominal infection in mice. J Mol Med 60:702–704
McCallum RE, Urbaschek R, Ditter B, Urbaschek B (1983) Host response to mixed anaerobic infection with Bacteroides melaninogenicus and Fusobacterium necrophorum. Infection 11:35–40
Sabbaj J, Sutter VL, Finegold SM (1972) Anaerobic pyogenic liver abscess. Annual Intern Med 77:629–638
Sheehan G, Harding G (1989) Intraperitoneal infections. In: Finegold SM, George WL (eds) Anaerobic infections in humans. Academic Press, San Diego, pp 349–384
Willis AT (1991) Abdominal sepsis. In: Duerden BI, Drasar BS (eds) Anaerobes in human disease. New York, Wiley-Liss, pp 197–223
Acknowledgments
The authors wish to thank Dr. Kaori Sakamoto, Department of Veterinary Pathology, University of Georgia, for her constructive comments and Mr. M. Mohammadnejad and Mrs. T. Gholamhoseini Moghadam for laboratory processing.
Author information
Authors and Affiliations
Corresponding author
Rights and permissions
About this article
Cite this article
Movassaghi, A.R., Rad, M. A rare case of septicemia due to Bacteroides melaninogenicus in a Holstein cow. Comp Clin Pathol 19, 409–411 (2010). https://doi.org/10.1007/s00580-010-0957-x
Received:
Accepted:
Published:
Issue Date:
DOI: https://doi.org/10.1007/s00580-010-0957-x

